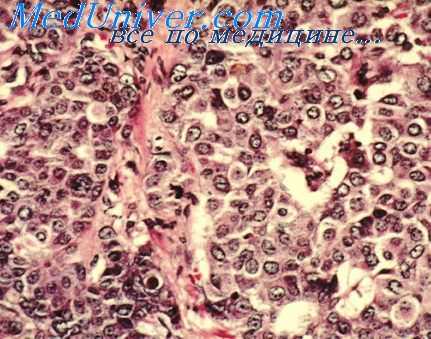

Лейкопоэз на фоне острой лучевой болезни. Сепсис на фоне радиационной пневмонии
Добавил пользователь Владимир З. Обновлено: 20.11.2025
Удельный вес лейкопенических состояний среди других заболеваний системы крови довольно велик. Статистические данные свидетельствуют об увеличении за последние годы числа больных с выраженной лейкопенией. Нередко развитие данной патологии находится в определенной связи с применением в лечебной практике новых бактериостатических средств, с воздействием ионизирующей радиации, а также с увеличением эпизодов аллергических заболеваний. В оценке лейкопенических состояний врачу следует избегать двух противоположных тенденций: в одних случаях отсутствует должное внимание к лейкопении, являющейся началом тяжелой патологии системы крови, и не принимаются необходимые профилактические и лечебные меры, в других -любое снижение количества лейкоцитов расценивается как симптом тяжелой патологии с необоснованным применением сильнодействующих лейкопоэтических средств (средств, усиливающих интенсивность образования указанных форменных элементов крови). Поэтому для правильной оценки значения «индивидуальной» лейкопении необходимо по возможности выяснить ее причины и механизм развития, так как только подобное решение вопроса обеспечивает успех лечебно-профилактических мероприятий в каждом отдельном случае. Лейкопении часто сочетаются со значительным уменьшением количества нейтрофилов в периферической крови, поэтом– по своей сути они являются нейтропениями или гранулоцитопениями (соответственно снижение количества нейтрофилов и гранулоцитов).
Причины гранулоцитопении при всем их разнообразии разделяются на экзогенные (действующие извне), эндогенные (возникающие в самом организме) и наследственные. К первой группе факторов относятся некоторые вещества, которые обладают токсическим действием, такие как бензол, толуол, мышьяк, ртуть; некоторые лекарственные препараты; радиация; инфекционные заболевания.
Эндогенными причинами нейтропении могут являться нарушение эндокринной регуляции гранулоцитопоэза, т. е. образования гранулоцитов (тиреотоксикоз, недостаточность функции надпочечников, нарушение функции гипофиза), повышение функции селезенки, аллергические состояния.
Перечисленные лейкопении относят к группе функциональных. Но лейкопения и нейтропения могут быть проявлением нарушения костномозгового кроветворения при системной патологии крови: остром лейкозе, гипо– и апластических состояниях. В ряде случаев не удается выявить причинный фактор, приводящий к развитию гранулоцитопении. В последнее время таких форм становится все меньше.
В последние годы выделяется особая группа наследственных нейтропении (постоянные и периодические нейтропении). Кроме того, лейкопении могут носить симптоматический характер в виде непостоянного гематологического признака при некоторых заболеваниях.
Умеренные бессимптомные лейкопении без каких-либо клинических проявлений обнаруживаются случайно, являются одним из второстепенных и необязательных симптомов разных заболеваний. Характеризуются умеренным снижением количества лейкоцитов (до 3,0-4,0 Ч 109/л) и нерезкой гранулоцитопенией (40-60% от общего числа нейтрофилов). Функциональные свойства лейкоцитов не изменены. Миелопоэз не нарушен. Костный мозг нормален. Не отмечается также изменений формирования эритроцитов и тромбоцитов. Подобные лейко- и нейтропении носят чаще всего чисто симптоматический характер, сопровождая ряд заболеваний, не относящихся к системе крови (тиреотоксикоз, гастриты, энтероколиты, холециститы и многие др.).
Резко выраженная лейкопения сопровождается обычно резким понижением количества нейтрофилов в периферической крови и носит название агранулоцитоза.
Очень важно определить, когда с уверенностью можно говорить о лейкопении. В существующих руководствах по гематологии и физиологии, а также в сп–авочниках указывается нормальное содержание лейкоцитов, которое составляет 6,08,0 Ч 109/л, и врач при оценке патологических сдвигов исходит из этих цифр.
В последние годы внимание гематологов всех стран привлекает тот факт, что при отсутствии какой-либо патологии у совершенно здоровых людей обнаруживается пониженное количество лейкоцитов (от 4,0 до 2,0-2,5 Ч 109/л) с умеренной нейтропенией и относительным лимфоцитозом в лейкоцитарной формуле. В этой связи были проведены массовые исследования периферической крови здоровых лиц, что позволило расширить суженную норму количества лейкоцитов от 4,0 до 9,0 Ч 109/л. В повседневной практике содержание лейкоцитов менее 4,0 Ч 109/л можно расценивать как лейкопению, а более 9,0 Ч 109/л - как лейкоцитоз. Расширены и пределы нормальных колебаний процентного содержания палочкоядерных нейтрофилов до 7%, моноцитов - до 10%, лимфоцитов - от 19 до 40%, эозинофилов – до 5%. Поэтому те случаи, когда имеются низкие цифры лейкоцитов (до 4,0–3,0 Ч 109/л), при которых тщательное клинико-гематологическое обследование и последующее наблюдение не обнаруживают какой-либо патологии, могут расцениваться как «безопасная лейкопения». В развитии такой лейкопении имеет значение прежде всего индивидуальная конституциональная особенность регуляции кроветворения у каждого человека. В таких случаях не требуется никакой терапии, стимулирующей образование в костном мозге и выход в периферическую кровь лейкоцитов.
В основе агранулоцитоза лежит клинико-гематологический синдром, характеризующийся полным или почти полным исчезновением гранулоцитов из периферической крови. За агранулоцитоз следует принимать состояние, характеризующееся снижением числа лейкоцитов до 1 Ч 109/л (1000 в 1 мм3) и ниже с падением абсолютного числа зернистых лейкоцитов менее 0,5 Ч 109/л (150 в 1 мм3).
Патогенез (что происходит?) во время Лейкопении и агранулоцитозы:
Агранулоцитоз разделяется на две основные формы: миелотоксический и иммунный.
Причиной миелотоксического агранулоцитоза могут быть цитостатические факторы любой природы - химиопрепараты (меркаптопурин, метотрексат, циклофосфан, миелобромол, Тио-Тэф), ионизирующая радиация, а также некоторые медикаменты, не использующиеся как химиопрепараты с цитостатической целью, но обладающие иногда подобным побочным эффектом (левомицетин, аминазин).
Механизм миелотоксического агран–лоцитоза обусловлен подавлением цитостатическими факторами клетки предшественницы миелопоэза или полипотентной стволовой клетки.
Аналогичная гематологическая картина наблюдается при острых лейкозах, в терминальной стадии хронического миелолейкоза, метастазах в костный мозг, рака и саркомы, также вызывающих угнетение и остановку нормального кроветворения, следствием чего является агранулоцитоз.
Иммунный агранулоцитоз в отличие от миелотоксического обусловлен не остановкой продукции нейтрофилов, а их гибелью в крови и костном мозге, иногда вплоть до клеток-предшественниц гранулоцитарного ряда вследствие появления антигранулоцитарных антител (антител против гранулоцитов). Различают гаптеновый иммунный агранулоцитоз и аутоиммунный. Первый возникает под воздействием лекарственных препаратов, являющихся гаптенами (неполными антигенами), к которым относятся аминодопирин, анальгин, бутадион, сульфаниламиды, метилтиоурацил, ртутные, мочегонные, противотуберкулезные препараты - ПАСК, фтивазид, тубазид. Соединение антител с антигенами, фиксирующимися на поверхности лейкоцитов, сопровождается агглютинацией («склеиванием») и гибелью клеток. При аутоиммунном агранулоцитозе антилейкоцитарные антитела (антитела против лейкоцитов) возникают вследствие извращенной реакции иммунной системы с образованием аутоантител к лейкоцитам с неизмененной антигенной структурой. Часто наблюдаются при больших коллагенозах (системная красная волчанка, ревматоидный полиартрит).
В развитии миелотоксического агранулоцитоза решающая роль принадлежит величине повреждающего воздействия - дозам медикамента, ионизирующей радиации, степени подавляющего эффекта атипичных клеток при опухолевых процессах. При иммунном агранулоцитозе доза причинного фактора не имеет решающего значения, так как важнейшая роль в данном случае принадлежит индивидуальной чувствительности организма.
Симптомы Лейкопении и агранулоцитозы:
В клинических проявлениях миелотоксического и иммунного агранулоцитозов имеются различия. Иммунный агранулоцитоз, связанный с приемом медикаментов гаптенового ряда, чаще развивается остро, с быстрым нарастанием симптомов. Вскоре после приема медикаментов развиваются гранулоцитопения или агранулоцитоз, высокая лихорадка и быстрое присоединение инфекционных осложнений (ангина, стоматит, кандидамикоз носоглотки, иногда - и слизистой пищевода). Септические осложнения представляют основную опасность для жизни больного. Некротическая ангина является классическим проявлением агранулоцитоза. На миндалинах обнаруживаются грязно-серый налет, затем - некроз и язвы. Некротизация захватывает язычок, мягкое и твердое небо; часто возникает кровотечение. Однако некрозы могут локализоваться также в кишечнике, протекая с тифоподобной картиной, в пищеводе, мочевом пузыре, женских половых органах. В легких нередко развивается пневмония, которая протекает атипично, часто приводит к образованию абсцесса, гангрены. Печень может быть умеренно увеличена, размеры селезенки, как правило, не изменены. Желтуха встречается довольно редко; в моче - умеренная альбуминурия (белок в моче), связанная с септическим состоянием.
При иммунном агранулоцитозе со стороны крови отмечается лейкопения, абсолютный агранулоцитоз. Число эритроцитов, ретикулоцитов, тромбоцитов не изменено. Геморрагический синдром не выражен. Костный мозг не опустошен, наблюдается небольшое снижение его клеточного состава. Лишь при обострениях агранулоцитоза наступает опустошение костного мозга.
Миелотоксический агранулоцитоз имеет особенности клинической и гематологической картины, что определяется спецификой его развития - высокой чувствительностью к повреждению стволовых и созревающих клеток костного мозга и очень малой чувствительностью зрелых элементов. Он начинается внезапно. Без каких-либо субъективных признаков болезни в крови снижается содержание лейкоцитов и, как правило, ретикулоцитов и тромбоцитов. Первые внешние признаки болезни: лихорадка, стоматит, «агранулоцитарная ангина», геморрагический синдром - выявляются на фоне глубоких изменений в периферической крови и резкого снижения клеточности костного мозга.
В то же время поражение слизистой оболочки ротоглотки и желудочно-кишечного тракта с развитием некротической энтеропатии является одним из наиболее постоянных признаков миелотоксического агранулоцитоза, имеющим двоякое происхождение.
К инфекционным осложнениям агранулоцитоза относятся также сепсис (нередко стафилококковый), медиастинит (воспаление средостения) и пневмонии. При этом пневмонии протекают на фоне скудных физикальных и рентгенологических данных.
Диагностика Лейкопении и агранулоцитозы:
Диагноз агранулоцитоза следует обязательно дифференцировать с острым лейкозом (его лейкопенической формой).
Диагностические ошибки возможны в обоих направлениях, чаще всего это касается морфологических ошибок, когда значительный процент лимфобластов принимают за лимфоциты, поскольку и те и другие имеют некоторые черты сходства. В ряде случаев возможен «агранулоцитарный старт» острого лейкоза, который в начале заболевания ошибочно квалифицируется как агранулоцитоз. В дальнейшем же развивается типичная лейкемическая стадия острого лейкоза. В отличие от апластической анемии при агранулоцитозе нет анемического и тромбоцитопенического синдрома.
Прогноз при пластических (функциональных) формах агранулоцитоза благоприятный, в течение 2-3 недель наступают клиническое выздоровление и полная репарация (восстановление) крови. При апластических формах прогноз более серьезен, однако при своевременной и обоснованной терапии возможно выздоровление.
Признаком начинающегося восстановления кроветворения у больных агранулоцитозом является моноцитоз (увеличение количества моноцитов) с наличием их предшественников в крови.
Лечение Лейкопении и агранулоцитозы:
Основная роль в борьбе с цитопеническими состояниями принадлежит профилактике. Учитывая выраженные воздействия лучистой энергии, производных бензола, необходимы строгие меры защиты лиц, систематически подвергающихся воздействию этих факторов. Одними из таких мероприятий являются контроль за составом крови у них и своевременные мероприятия по обеспечению мер безопасности. Это определяет наиболее эффективную форму динамического клинико-гематологического контроля - диспансерное наблюдение всех лиц с лейкопенией, нейтропенией и цитопенией.
Далеко не каждое снижение количества лейкоцитов требует энергичной, стимулирующей образование лейкоцитов терапии. Такая терапия необходима там, где лейкопения является следствием нарушения функции костного мозга. Терапевтические мероприятия при лейкопениях различного происхождения зависят от их выраженности и клинических проявлений. В настоящее время в клинике применяется значительное количество препаратов, обладающих способностью стимулировать созревание гранулоцитов. К их числу относятся нуклеиновокислый натрий, пентоксил, лейкоген, батилол, которые являются физиологическими стимуляторами лейкопоэза. Однако лечебная эффективность этих препаратов оправдана лишь при умеренной лейкопении, особенно медикаментозной.
В лечебной тактике агранулоцитоза необходимо исключение цитостатических препаратов, ионизирующего излучения, медикаментозных гаптенов. Особое значение имеет создание асептических условий (помещение больных в боксы или изоляторы с установленными бактериоцидными лампами, ультрафиолетовое облучение палат), санация кожи и слизистых оболочек.
Лечение бактериальных осложнений антибиотиками должно быть неотложным с первых дней диагностирования агранулоцитоза. Используются антибиотики широкого спектра и в больших дозах (пенициллин, ампициллин, цепорин, гентамицин).
При иммунном агранулоцитозе лечение антибиотиками проводят до восстановления лейкограммы и ликвидации бактериальных осложнений. С целью снижения степени гранулоцитопении и ее продолжительности важно применение лейкоцитарной, а для борьбы с тромбоцитопеническими кровотечениями (главным образом, при миелотоксической форме агранулоцитоза - цитостатической болезни) - и тромбоцитарной массы. Для профилактики и лечения некротической энтеропатии используют подавление патогенной кишечной флоры со стерилизацией кишечника при помощи антибиотиков (канамицин, ристомицин, нистатин), а также внутривенное питание больных. В терапии иммунного агранулоцитоза основную роль играют кортикостероидные гормоны.
Преднизолон, преднизон, триамоинолон, дексаметазон используются как средства десенсибилизирующие, подавляющие образование агрессивных антител и стимулирующие созревание гранулоцитов. Восстановление белого ростка костного мозга в таких случаях идет быстро. С нормализацией числа лейкоцитов, обычно через 10-14 дней, доза гормонов сокращается не менее чем наполовину. Лечение гормонами прерывистыми курсами продолжается до полного выздоровления и до исчезновения аутоиммунных антител. При выраженных язвенно-некротических проявлениях необходима известная осторожность в отношении использования кортикостероидов. Больным миелотоксическим агранулоцитозом стероидные гормоны противопоказаны.
Прогноз при иммунном агранулоцитозе относительно благоприятен. Раннее и правильное лечение может привести к выздоровлению. При миелотоксическом агранулоцитозе прогноз зависит от тяжести поражения. Общая летальность при агранулоцитозе - около 25%, в основном за счет некротической энтеропатии, общего сепсиса, гангрены, чаще - при миелотоксической форме.
Лица, болевшие агранулоцитозом, нуждаются в диспансерном наблюдении. Это особенно относится к тем больным, которые выписываются из стационара в удовлетворительном состоянии с достаточным числом лейкоцитов (3000–4000), но нередко с низким содержанием гранулоцитов. Это свидетельствует о недостаточном и неустойчивом восстановлении кроветворения. Периодический гематологический контроль периферической крови больных позволяет обнаружить постепенное падение числа гранулоцитов. Профилактика реальна при условии известной причины развития данного заболевания. В частности, должен быть абсолютно исключен медикамент, вызвавший агранулоцитоз или лейкопению.
К каким докторам следует обращаться если у Вас Лейкопении и агранулоцитозы:
Вас что-то беспокоит? Вы хотите узнать более детальную информацию о Лейкопении и агранулоцитозы, ее причинах, симптомах, методах лечения и профилактики, ходе течения болезни и соблюдении диеты после нее? Или же Вам необходим осмотр? Вы можете записаться на прием к доктору .
Лейкопоэз на фоне острой лучевой болезни. Сепсис на фоне радиационной пневмонии
Возбудители лучевой пневмонии. Клеточная реакция после радиационного поражения
Чаще всего пневмония возникает вследствие аутоинфицирования микрофлорой верхних дыхательных путей и бронхов [Сосова В. Ф., 1956]. Инфицирование может происходить и за счет микробов, проникающих в легкие из внешней среды, так как легочный барьер в условиях лучевой болезни становится проницаемым не только для патогенных, но и для непатогенных микроорганизмов [Иванов А, Е., Сосова В. Ф., 1956]. При микроскопическом исследовании легких облученных животных в зоне кровоизлияний или массивного отека в большом количестве обнаруживаются скопления микроорганизмов, относящихся главным образом к кокковой флоре и кишечным бактериям.
В подобных случаях, как правило, налицо деструктивные изменения, но далеко не всегда отмечаются морфологические признаки воспалительной реакции. Однако по периферии таких очагов всегда можно различить слабую клеточную реакцию в виде немногочисленных мононуклеарных клеток, десквамации эпителия или выпадения фибрина. Отсутствие выраженной лейкоцитарной реакции, естественно, затрудняет решение вопроса о том, что имеется прижизненная инфекция, предагональная инвазия или посмертное размножение микроорганизмов.
Наряду с бронхогенным инфицированием возможен и гематогенный занос микроорганизмов из кишечника. Об этом свидетельствуют обнаруживаемые иногда в кровоизлияниях или в воспалительных очагах грамотрицательные бактерии. Убедительным подтверждением прижизненного распространения кишечной флоры является наличие микробов в мелких сосудах и капиллярах легких и других органов.
Воспалительные изменения в легких могут быть обусловлены и грибковой инфекцией вследствие резкого снижения местного и общего иммунитета на высоте лучевой болезни,

Таким образом, причины возникновения воспалительных осложнений в легких при острой лучевой болезни могут быть довольно разнообразными, хотя значение бронхогенного инфицирования все же остается основным. В этом случае микроокоати'чееки на фоне расстройства кровообращения и повышенной проницаемости сосудистых стенок различаются очаги серозно-геморрагической бронхопневмонии. Отличительной чертой таких очагов является бедность воспалительного экссудата клеточными элементами.
Почти полностью отсутствуют нейтрофильные лейкоциты и пролиферация местных клеток в экссудате, заполняющем просветы альвеол, перибронхиалыше пространства и бронхи, определяются гемолизированные эритроциты, немногочисленные измененные клетки альвеолярного и бронхиального эпителия, мононуклеарные клетки со слабовыраженными признаками фагоцитоза, фибрин и микроорганизмы. В зависимости от тяжести поражения сосудов в экссудате преобладают серозная жидкость, фибрин или эритроциты. Кроме того, в мелких бронхах всегда имеется массивная десквамация эпителия, деструкция и некроз стенок, обилие микроорганизмов в просветах и в перибронхиальной ткани.
Присутствие микроорганизмов в сочетании с деструктивными изменениями в бронхах, расположенных вне зоны кровоизлияний и отека, по-видимому, является достаточно надежным признаком для положительного решения вопроса о наличии пневмонии. Однако в зависимости от периода лучевой болезни, тяжести поражения и индивидуальных особенностей организма преобладание альтеративных и экссудативных компонентов воспаления, а также слабая клеточная реакция со стороны местных клеток, макро- и микрофагов проявляются по-разному. Иногда на первый план выступают экссудативные явления. Тогда воспалительный экссудат может состоять или из серозной жидкости с примесью того или иного количества фибрина, немногочисленных фагоцитов, десквамированных клеток альвеолярного эпителия, эритроцитов и микроорганизмов, или почти сплошь из одного фибрина с наличием отдельных клеток и микробов.
В других случаях обращают на себя внимание грубые деструктивные изменения в бронхах и респираторных отделах легочной ткани. Иногда это сочетается со скоплением фагоцитов или преобладанием десквамации альвеолярного и бронхиального эпителия. Наконец, что бывает реже всего, несмотря на выраженную лейкопению, в экссудате обнаруживаются в значительном количестве полиморфно-ядерные лейкоциты.
Информация на сайте подлежит консультации лечащим врачом и не заменяет очной консультации с ним.
См. подробнее в пользовательском соглашении.
Лейкоцитарная реакция при радиационной пневмонии. Реакция легочной ткани на воспаление при лучевой болезни
При заражении в самом начале острой лучевой болезни общая лейкоцитарная реакция в периферической крови отличается замедленным развитием. Инфицирование в первые часы не вызывает заметного увеличения количества лейкоцитов, а наоборот, усугубляет развитие лейкопении, обусловленной действием ионизирующего излучения. Затем наступает период более или менее выраженного относительного лейкоцитоза, который удерживается не более 4—5 сут.
После этого содержание лейкоцитов в крови становятся вновь очень низким несмотря на продолжающееся развитие инфекционного процесса. Лишь на фоне восстановления кроветворения в исходе лучевой болезни наступает постепенное повышение содержания лейкоцитов в периферической крови. Следует заметить, что возникающие в начале острой лучевой болезни воспалительные процессы в других органах и ткааях морфологически мало чем отличаются от обычных [Шиходыров В. В., 1957; Пономарьков В, И., 1958].
Однако данное представление, очевидно, справедливо лишь в отношении местных тканевых воспалительных изменений. Что касается общей реакции организма, то и в начале острой лучевой болезни она может проявляться в необычном виде. Изложенное хорошо подтверждается особенностями температурной реакции облученного организма на развитие инфекционного процесса.
При экзогенном инфицировании в течение 1-х суток после облучения повышение температуры тела наступает позже и впоследствии бывает более высоким, чем при развитии пневмонии в необлученном организме.

При возникновении пневмонии на высоте острой лучевой болезни характер я динамика развития воспалительного процесса существенно отличаются от описанной. Воспаление сразу же принимает выраженный геморрагический оттенок. Больших размеров достигают явления геморрагического диатеза и отека. Поэтому пневмонические очаги имеют значительную плотность и по внешнему виду напоминают кровоизлияния, но в отличие от последних имеют зернистую поверхность на разрезе.
Отсюда возможны ошибки в макроскопической диагностике пневмоний при острой лучевой болезни. Микроскопически воспаление проявляется главным образом в резком расширении и полнокровии кровеносных сосудов и капилляров, плазматическом пропитывании и гомогенизации их стенок, обширных диапедезных кровоизлияний с гемолизом эритроцитов, скоплении в альвеолах, альвеолярных ходах и межуточной ткани большого количества серозной жидкости и фибрина. При этом с трудом различаются небольшие перибронхиальные инфильтраты из круглых клеток и единичных полиморфно-ядерных лейкоцитов.
Вместе с тем возможно развитие и более выраженной клеточной воспалительной реакции. В таких случаях имеется достаточно интенсивная лимфоцитарная и лейкоцитарная инфильтрация интерстпцпальной ткани. Но в отличие от воспалительных изменении, развившихся после заражения в начале острой лучевой болезни, в данном случае больших размеров достигает распад клеток, а фагоцитоз клеточного детрита выражен очень слабо.
Заслуживает внимания тот факт, что особенно скудная клеточная реакция при течении воспалительного процесса отмечается в начале восстановительного периода лучевой болезни, когда наступает максимальное истощение многих функций облученного организма. Поэтому морфологическая картина воспаленной легочной ткани скорее напоминает кровоизлияния или очаги ателектаза.
Только очень скудная лейкоцитарная инфильтрация в периваскулярной и перибронхиальной ткани, а также наличие микроорганизмов позволяют заподозрить воспалительную природу происходящих изменили.
Инфицирование на высоте острой лучевой болезни не вызывает существенного оживления нарушенного лейкопоэза и усиленного поступления из кроветворной ткали в кровеносное русло сохранившихся лейкоцитов. Поэтому есть основания думать, что относительный воспалительный лейкоцитоз связан с мобилизацией лейкоцитов из периферических кровяных депо. Эти наблюдения представляют значительный интерес хотя бы потому, что в литературе существует мнение о стимулирующем действии инфекционных воспалительных процессов на угнетенное кроветворение при лучевой болезни [Каляева Т. В., 1958].
При сопоставлении гематологических и бактериологических данных нетрудно убедиться, что прекращение относительного лейкоцитоза совладает с наступлением бактериемии, которая вызывает еще большее опустошение костного мозга и, в частности, угнетение лейкопоэза. Данное обстоятельство является примером того, насколько развитие местного инфекционного воспалительного процесса влияет на состояние системы крови облученного организма. Однако полного параллелизма между состоянием кроветворения и содержанием соответствующих клеточных элементов в воспалительном экссудате может не быть.
В некоторых случаях, несмотря на опустошение костного мозга, в очагах воспаления все же обнаруживается значительное количество лейкоцитов. Аналогичные наблюдения описаны и другими исследователями [Мудрецов Н. И., 1957; Яковлева Л. А., 1966] при изучении воспалительных изменений в других тканях и органах облученных животных. Это свидетельствует о возможности мобилизации сохранившихся лейкоцитов к воспалительному очагу.
При возникновении пневмонии в разгар острой лучевой болезни, как правило, микроорганизмы распространяются из воспалительного очага в кровь. Однако и в пределах указанного периода это происходит в зависимости от сроков инфицирования после облучения. Заражение в начале периода выраженных проявлений лучевой болезни сопровождается быстрым проникновением возбудителя из пневмонических очагов в кровь в течение 2 сут.
При возникновении пневмонии в более поздние сроки микроорганизмы обнаруживаются в крови не раньше чем через 2 сут после заражения, а предшествующая бактериемия за счет аутофлоры существенно не влияет на скорость распространения микробов из легких. В случае заражения в конце разгара острой лучевой болезни появление в крови экзогенных микроорганизмов регистрируется, как правило, через 3 сут от начала пневмонии. Относительная устойчивость легочного барьера к экзогенной инфекции наблюдается после заражения в самом начале лучевого заболевания. Все это свидетельствует об определенной динамике в состоянии иммунобиологических свойств организма даже в разгар заболевания.
Легочный барьер оказывается наиболее проницаем для экзогенной инфекции именно в начале периода выраженных явлений лучевого поражения, когда удовлетворительное состояние реактивных свойств облученного организма сменяется глубоким подавлением. Вместе с тем к концу периода выраженных проявлений острой лучевой болезни иммунное состояние организма оказывается достаточным, чтобы в течение нескольких дней препятствовать генерализации того же инфекционного агента. Однако следует иметь в виду, что барьерная функция легких и устойчивость организма в целом к генерализованной инфекции проявляется в. большей степени, если экзогенное заражение происходит до наступления восстановительного периода острой лучевой болезни.
Инфицирование в начале восстановительного периода может вызывать очень быстрый прорыв местного клеточного иммунитета с развитием массивной бактериемии и ранним смертельным исходом.
Таким образом, подтверждается относительность компенсаторно-приспособительных явлений в исходе острой лучевой болезни. Они могут быть достаточно эффективными в отношении предшествующих или развивающихся одновременно с лучевым поражением патологических процессов и оказываются несовершенными при действии нового инфекционного раздражителя в начале восстановительного периода.
- Вернуться в оглавление раздела "гистология"
Постлучевой пневмонит ( Радиационный пневмонит )
Постлучевой пневмонит – повреждение лёгочной ткани, развивающееся под действием высоких доз ионизирующей радиации. Проявляется одышкой, сухим или продуктивным кашлем, плевральными болями, сопровождается повышением температуры тела. Диагноз выставляется на основании анамнестических данных и клинических симптомов, подтверждается результатами спирометрии, рентгенологического исследования, компьютерной томографии и МРТ органов грудной клетки. Лечение пневмонита проводится с помощью фармакотерапии кортикостероидными гормонами, антибиотиками, антикоагулянтами; оксигенотерапии, физиотерапии.
МКБ-10


Общие сведения
Постлучевой пневмонит (лучевой пульмонит, радиационная пневмония) относится к локальным радиационным поражениям лёгочной паренхимы. Ионизирующим излучением повреждается участок альвеолярной ткани, отсюда другое название – лучевой альвеолит. Ярко выраженные клинические проявления встречаются у 15-60% получающих радиотерапию по поводу рака легких и молочной железы. В 3-4% случаев постлучевой пневмонит приобретает крайне тяжёлое течение и заканчивается летально. У некоторых больных протекает латентно, характерные изменения выявляются только специальными методами исследования.
Причины
Пусковым механизмом служит превышение толерантной дозы радиоактивного воздействия на лёгочную ткань. При лучевой терапии онкологических заболеваний грудной полости, рака молочной железы доза радиации составляет в среднем 70-80 Гр. В фокус облучения попадает зона лёгкого с предельной переносимостью 35-40 Гр, вследствие чего развиваются радиационные поражения. Частота возникновения, течение патологического процесса напрямую зависят от величины суммарной очаговой дозы. Большое значение имеют следующие факторы:
- Возраст пациента. Согласно исследованиям в области онкологии и пульмонологии, больные старше 70 лет страдают от осложнений радиотерапии в 1,5 раза чаще, чем 40-60-летние. У детей толерантность респираторных органов к лучевой нагрузке в 2,5 раза ниже, чем у взрослых.
- Локализация очага. Установлена прямая зависимость частоты радиационно-индуцированного пульмонита от расположения очага, на который производится воздействие. Чем ближе по отношению к средостению находится фокус облучения, тем реже и позднее выявляются проблемы. Больше страдают периферические участки лёгких.
- Комплексное и комбинированное лечение. Сочетание радиотерапии с хирургическим лечением и (или) химиотерапией увеличивает количество случаев постлучевого пневмонита, провоцирует его раннее развитие, утяжеляет течение. Противоопухолевые препараты способны самостоятельно негативно воздействовать на дыхательную систему, вызывать пневмопатии.
Патогенез
Ионизирующее излучение повреждает клетки альвеолярного эндотелия. Нарушается продукция сурфактанта, альвеолы спадаются. Одновременно поражается внутренняя оболочка капилляров, что приводит к тромбообразованию, частичной закупорке и повышению проницаемости сосудов. Страдает газообмен. Изменения по типу экссудативного альвеолита возникают в первые дни. В течение 1-3 месяцев повреждённый эндотелий частично восстанавливается, происходит реканализация ряда сосудов. Активируются фибробласты, погибшие клетки заменяются соединительной тканью.
Макроскопически определяются полнокровные участки лёгочной паренхимы плотноэластической консистенции, фибринозный выпот в плевральной полости. При микроскопическом исследовании выявляется утолщение альвеолярной мембраны, повреждения капиллярной сети с признаками тромбоза, стаза и полнокровия. В области межальвеолярных перегородок формируются зоны фиброза.
Классификация
Острый постлучевой пневмонит является ранним радиационным повреждениям органов дыхания. Возникает на фоне облучения или в течение первых трёх месяцев после него. Стабильные изменения, обнаруженные в более поздние сроки, расцениваются как пневмофиброз. Американскими онкологами разработана классификация заболевания в зависимости от степени тяжести:
- I степень. Болевые ощущения в груди отсутствуют или минимальные. Кашель редкий. Одышка появляется при значительной физической нагрузке. Определяется снижение жизненной ёмкости лёгких (ЖЕЛ) на 10-25% от должного значения. Имеются косвенные рентгенологические признаки болезни.
- II степень. Больного беспокоит периодическая терпимая торакалгия, приступы кашля. При ходьбе ощущается нехватка воздуха. ЖЕЛ находится в пределах 50-75% от нормальной величины. На рентгенограмме видны очаговые тени.
- III степень. Боль становится интенсивной, кашель - постоянным. Одышка возникает при малейшей нагрузке. ЖЕЛ составляет 25-50 % от нормы. Размеры инфильтрации на снимке соответствуют облучённому участку.
- IV степень. Стойкий болевой синдром, непрекращающийся кашель требуют назначения наркотических анальгетиков. Дыхание затруднено в покое. Наблюдается значительное (более чем на 75%) снижение ЖЕЛ. При рентгенографии выявляется одностороннее субтотальное или тотальное затенение. Пациент нуждается в респираторной поддержке.
Симптомы постлучевого пневмонита
Заболевание начинается остро. Ведущим симптомом является кашель. Его интенсивность варьирует от редкого покашливания до постоянных мучительных приступов. Может отделяться светлая слизистая мокрота, которая при присоединении вторичной инфекции становится гнойной жёлто-зелёной. Иногда возникает кровохарканье. Одышка вызывается нагрузкой, в тяжёлых случаях беспокоит при разговоре, в состоянии покоя. Боль в груди может отсутствовать или появляться эпизодически; при наличии фибринозного плеврита становится постоянной и интенсивной. Температурная реакция колеблется от стойкого субфебрилитета до гипертермии.
Классической клинической картине иногда предшествует общая лучевая реакция. Пациент становится излишне раздражительным, предъявляет жалобы на слабость, головную боль, головокружение, бессонницу. Развивается миокардиодистрофия, возникают перебои в сердечной деятельности. Нарушения работы пищеварительного тракта проявляются тошнотой, рвотой, диареей. Резко снижается аппетит, наблюдается извращение вкуса, избыточное отделение слюны.
Осложнения
Небольшой по объёму постлучевой пневмонит часто распознаётся несвоевременно. Обнаруживается на стадии пневмофиброза с бронхоэктазами, плевродиафрагмальными спайками, смещением средостения. Из-за массивного склеротического процесса возникают необратимые дыхательные нарушения. Формируется хроническое лёгочное сердце, значительно ухудшается качество жизни. При обширных изменениях развивается тяжёлая острая дыхательная недостаточность, требующая перевода на искусственную вентиляцию лёгких. Может наступить летальный исход.
Диагностика
Чёткая связь респираторных нарушений с проводимой радиотерапией позволяет пульмонологу заподозрить постлучевой пневмонит. При сборе анамнеза уточняются дозы, количество и давность сеансов облучения, сочетание с химиотерапией или операцией. Особое внимание уделяется локализации и размерам очага. Следует учитывать наличие общей реакции. Основные диагностические мероприятия включают:
- Физикальное исследование. Определяются зоны притупления перкуторного звука на стороне поражения. Аускультативно выслушиваются непостоянные средне- и мелкопузырчатые хрипы, шум трения плевры.
- Лабораторные анализы. Такие проявления лучевой реакции, как угнетение гемопоэза, иммунные нарушения, выявляются лабораторными методами. В клиническом анализе крови наблюдается снижение уровня лейкоцитов, тромбоцитов, эозинофилия.
- Рентгенография и КТ лёгких. На рентгенограмме заметны усиление и деформация лёгочного рисунка, фокусы инфильтрации в проекции зоны облучения, плевральный выпот. Одностороннее поражение является патогномоничным признаком заболевания. КТ позволяет раньше выявить и более точно определить границы повреждения.

КТ органов грудной клетки. Снижение пневматизации в периферических отделах правого легкого после лучевой терапии по поводу рака молочной железы.
Дополнительно выполняется исследование газового состава крови и функции внешнего дыхания. В неясных случаях для уточнения диагноза используется МРТ. Постлучевой пневмонит следует дифференцировать с метастатическим обсеменением, бактериальной пневмонией, а также с туберкулёзом и микозами, которые могут быть спровоцированы вторичным иммунодефицитом.
Лечение постлучевого пневмонита
При подтверждении радиационной пневмонии назначается консервативная терапия. Применяются фармакологические средства, физиотерапевтические методы, лечебная физкультура. Основные мероприятия направлены на снижение смертности, восстановление респираторных функций организма, минимизацию последствий. Для достижения терапевтического эффекта комплексно используются следующие группы препаратов:
- Системные кортикостероиды. Назначаются с целью стимуляции продукции сурфактанта. Уменьшают воспалительную реакцию лёгкого, сглаживают симптомы. Положительный ответ наступает быстро, обычно на 2-4 день. Если за этот промежуток времени состояние пациента не улучшилось, дальнейшее применение кортикоидных гормонов не имеет смысла.
- Антикоагулянты. Препятствуют образованию тромбов в капиллярах малого круга кровообращения. Снижают риск развития смертельно опасного осложнения – тромбоэмболии лёгочной артерии.
- Антибиотики. Применяются для лечения бактериальных осложнений в условиях снижения иммунитета. Назначаются с учётом чувствительности микрофлоры мокроты к антибактериальным средствам. При отсутствии данных предпочтение отдаётся препаратам с широким спектром действия.
Дополнительно используются отхаркивающие средства, ангиопротекторы, аскорбиновая кислота. При острой респираторной недостаточности показаны наркотические противокашлевые препараты, кислородная поддержка. Из физиотерапевтических методов рекомендуются ингаляции с димексидом, переменные магнитные поля. В восстановительном периоде широко применяются массаж и дыхательная гимнастика.
Профилактика и прогноз
Для предотвращения нежелательных реакций при проведении лучевой терапии пациенту рекомендуется сбалансированное калорийное питание, прогулки на свежем воздухе. Необходимо контролировать показатели крови, общее состояние больного. При появлении тромбопении, лейкопении, кровохарканья лучевую терапию следует прекратить. Рациональный индивидуальный подход, использование методов фигурных полей облучения позволяют значительно снизить частоту возникновения индуцированных радиацией осложнений. При радикальной радиотерапии рака лёгкого в профилактических целях рекомендуется одновременное переливание облучённой аутокрови, использование энтеросорбентов.
Прогноз во многом определяется течением основного заболевания, площадью повреждения лёгкого. Адекватно пролеченные небольшие пульмониты нередко подвергаются обратному развитию. Формирование фиброза продолжается от 6 месяцев до 2 лет, после чего изменения носят стабильный характер, и нарушения становятся необратимыми. Реабилитационные мероприятия способны влиять на процесс фиброзирования. Острый респираторный дистресс-синдром в ряде случаев заканчивается смертью.
1. Постлучевой пневмонит в практике пульмонолога/ Семищева Н. Л., Карапетян Е. И., Мальцева Т. А., Авдеева Н. В., Одиреев А. Н.// Бюллетень физиологии и патологии дыхания. – 2014.
2. Лучевые пневмониты у больных раком легкого/ Курсова Л.В., Иванова И.Н., Мардынский Ю.С., Золотков А.Г., Рагулин Ю.А.// Сибирский онкологический журнал. – 2010 - №2 (38).
3. Клинические рекомендации по оказанию медицинской помощи пострадавшим от воздействия ионизирующего излучения в чрезвычайных ситуациях. – 2013.
4. Поздние лучевые повреждения органов грудной клетки/ Пасов В.В., Зубова Н.Д., Иволгин Е.М., Курпешева А.К.// Сибирский онкологический журнал. – 2009 - №6 (36).
Читайте также:
